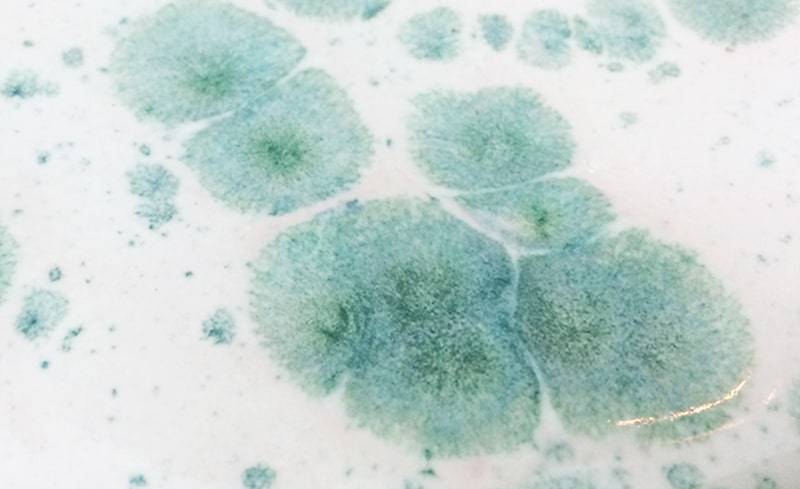

El cristal y la cerámica tienen elementos comunes en cuanto a transformación y vitrificación, así como en algunos casos, a translucidez. De esta forma, podemos combinar piezas de cerámica (ya transformadas, cocidas), con cristales, y unir ambos elementos. Os damos algunas ideas y materiales que podéis utilizar.

Una forma sencilla de emplear cristales en cerámica, es moler el vidrio de las botellas convencionales y rellenar una pieza con ellas. Es muy importante en este caso, que la pieza sea recipiente, para que no haya accidentes en el horno. Que tenga unas paredes lo suficientemente grandes para evitar que se derrame el cristal. Sin embargo, el color que dan estos cristales es inestable y muy limitado, así como de uso reducido, sólo con pastas de alta temperatura.
Por otro lado, estos cristales no pueden aplicarse en superficies verticales.
Para resolver algunos de estos inconvenientes, en el mercado existen varias opciones que van desde cristales sueltos con una amplia gamas de colores, para combinar con esmaltes propios o comerciales, a esmaltes ya preparados que contienen cristales.
En tienda Marphil contamos con las siguientes variedades:
Cristales granulados
Son cristales triturados que se presentan en bolsas de 250gr. Con ellos se pueden rellenar fondos cóncavos, piezas planas o grietas que hayamos realizado en una pieza. A diferencia del vidrio de botellas, la gama de colores que hay es amplia, los resultados muy estables y los colores vivos.
La temperatura de cocción es media y más limitada, en un rango de entre 1110ºC y 1150ºC.

Gamas Duncan Crystal Chips
Se trata de cristales secos de distintos colores que se pueden añadir a esmaltes creados por nosotros mismos, permitiéndonos jugar con los efectos y creando piezas únicas. Aportan efectos parecidos a los esmaltes comerciales de Mayco y Duncan.
La gran ventaja además es que se pueden usar en baja y alta temperatura, pudiendo encajar a la perfección con cualquier estilo de trabajo.
En plano, el resultado será más estable y definido, apareciendo lunares más o menos controlados, pero aplicados en piezas verticales descolgarán y fundirán con el esmalte sobre el que los hemos aplicado y crearán efectos sorprendentes.

Esmaltes Duncan
Duncan también ofrece una gama de esmaltes de baja temperatura que ya contiene cristales. Son esmaltes en suspensión, muy fáciles de usar.

Esmaltes Botz
La ventaja de estos esmaltes es que se puede escoger la cantidad de cristal que aplicas y dónde, porque se identifican muy bien los gránulos dentro del esmalte. Si bien la gama de color es más reducida, los cristales son grandes y el efecto que producen al romper es muy llamativo.
Esmaltes Mayco
Mayco tiene otra gama de esmaltes en suspensión que contiene cristales de colores elegantes y efectistas. Morados, rosas, azules turquesa… son algunos de los colores que podréis encontrar.
